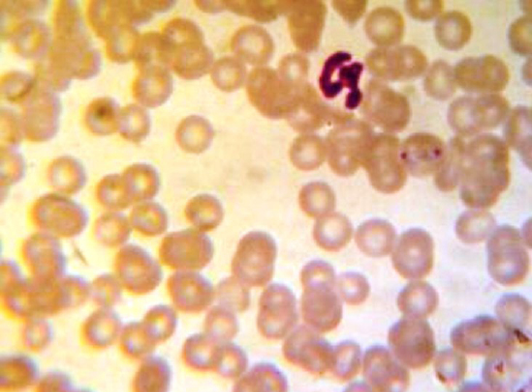

Research Journal for Veterinary Practitioners
Case Report
Res. J. Vet. Pract. 4(2): 30-33
Figure 1
Microscopic picture of blood smear with babesia organisms
Figure 2
Enlarged lymph node and haemoglobinuria
Figure 3
Icteric conjunctival mucous membranes
Figure 4
Icteric vaginal mucous membranes